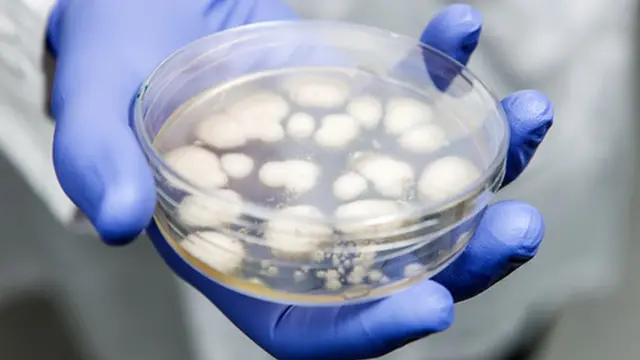
Penicillium fungus

Ученые: духовые инструменты могут быть опасны для здоровья

Автор фото, Thinkstock
Игра на тромбоне, саксофоне, волынке может навредить легким, предупреждают британские ученые и советуют музыкантам более тщательно чистить духовые инструменты.
Врачи описывают в медицинском журнале Thorax редкий случай 61-летнего пациента, который умер от болезни, вызванной плесенью, бактериями и грибками, которые размножились в мехах его волынки.
Известны еще несколько задокументированных случаев заболеваний музыкантов, игравших на саксофоне и тромбоне. К счастью, тогда жизни пациентов удалось спасти.
Ученые советуют музыкантам обратить внимание на такие симптомы, как кашель или одышка, и подумать, не связаны ли они с его профессиональной деятельностью.
Врачи настоятельно рекомендуют музыкантам уделять гигиене своих инструментов особое внимание.
Чтобы предотвратить развитие болезнетворных микроорганизмов необходимо регулярно чистить музыкальные инструменты.
Автор фото, SPL
Болезнь с каждым вдохом
Заболевание, которое описывают врачи, развивается, когда иммунная система организма начинает работать на пределе своих возможностей.
Болезнетворные микроорганизмы, вдыхаемые из музыкального инструмента, вызывают воспаление, которое при отсутствии лечения оставляют рубцы на легких.
Врачи больницы в Уайтеншо в Манчестере предполагают, что в случае с умершим мужчиной своеобразным инкубатором опасных бактерий были меха волынки.
Скончавшийся пациент был большим любителем поиграть на волынке и репетировал ежедневно.
Мужчина чувствовал недомогание в течение нескольких лет. Исключение составляли лишь те периоды, когда он уезжал в командировку или отпуск и не брал волынку с собой.
Врачи направили волынку в лабораторию, чтобы проверить свои догадки.
Анализ показал, что меха инструмента были заполнены плесенью и грибком, которые хорошо развиваются во влажном микроклимате.
Легким пациента был нанесен непоправимый ущерб. Состояние мужчины резко ухудшилось, в течение нескольких недель он скончался.

Автор фото, Thinkstock
"Если диагностировать проблемы на ранней стадии и убрать первопричину заболевания, то можно дать положительный прогноз лечения", - говорит доктор Дженни Кинг из больницы Уайтеншо.
"Микроорганизмы, о которых идет речь, содержатся и в воздухе, но их концентрация мала, поэтому они не вызывают проблем. Похожие заболевания легких иногда встречаются у людей, работающих на фермах. Они сталкиваются с большим количеством заплесневелого сена", - продолжает врач.
"Я бы сказал, что чистить деревянные духовые инструменты нужно после каждой репетиции или выступления. Влага оседает в дальних уголках и трещинках, и этого нужно избегать. Влага может повредить дерево, поэтому мы тщательно чистим инструменты", - говорит волынщик Национального центра волынки в Глазго Эндрю Бова.
Музыкант чистит свою волынку при помощи специальных щеточек, а каждые полгода он промывает трубки волынки горячей водой.
"Как мне объяснили, мешок из козьей или овечьей шкуры [составная часть волынки] нужно промывать горячей водой и обеззараживать каждый год. Это помогает убить всех микробов и продлить жизнь инструмента", - говорит волынщик.
"Большинство музыкантов сейчас чаще используют мешки из синтетики. В этом случае мешки нужно расстегивать, чтобы дать им просохнуть", - говорит Бова.























